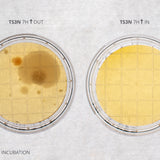

Laminar Flow Hood
A fully equipped laminar flow hood includes everything you need to create a clean air workspace. The continuous laminar air flow removes existing contamination from your workspace and prevents new contaminants from entering the hood and putting your experiments at risk.
Including a compatible HEPA filter and inbuilt UV light, the Ossila Laminar Flow Hood creates an ISO Class 5 clean air environment with 99.99% particle filtration. Spacious enough for effective and organized experimental setups, yet still the right size to fit straight onto your lab bench.
Jump to: Choose a hood | Buy a laminar flow hood | How to use | How do they work? | Resources
Choosing a Laminar Flow Hood
Horizontal vs Vertical Laminar Flow Hoods
Two main configurations, vertical and horizontal, are available. The difference between them is the direction of air flow through the hood—clean air will either flow horizontally or vertically. Each orientation offers distinct advantages depending on the application.
In horizontal laminar flow hoods, the filters are fixed to the back wall of the unit. Air is pulled from the back of the hood through the filter. The filtered air travels parallel to the work bench across the length of the hood and exits through the front opening. Whereas, in a vertical system, the filtered air is directed vertically through the workspace. At the work bench, the air flow is redirected out of the front panel. In these hoods, the filters are on the top panel of the unit.
A Configurable Option
Most systems are designed with a fixed orientation, requiring you to decide on the air flow direction before purchase. However, the Ossila Laminar Flow Hood can be configured in either orientation (and switched around if your requirements change), allowing you to setup the system according to your specific experimental needs.
Choosing the right setup is important to ensure the integrity and reliability of your results.
Vertical | Horizontal |
---|---|
|
|
|
|
|
|
|
|
|
|
|
|
Laminar Flow Hood vs Fume Hood
In lab environments, a laminar flow hood or fume hood creates a workspace with enhanced ventilation and filtration. However, they have different uses. It is crucial to understand their differences to formulate the correct experimental conditions and guarantee user safety. This article will help you choose between a laminar flow hood and a fume hood.
When to Use a Laminar Flow Hood
Laminar flow hoods (LFH) draw air from the room into the hood workspace. This air is filtered using high-efficiency particulate air (HEPA) filters. The clean air then circulates within the hood before flowing back into the room.
The clean and particle-free environment generated by a laminar flow hood is perfect for conducting low-contamination experiments. Contamination is pushed out of the hood by the flow of filtered air. A laminar flow hood is available in two configurations: horizontal and vertical. The direction of air flow differs between configurations and varies in the way it manages contamination.
Importantly, laminar flow hoods provide little protection for the user. When exiting the hood, the air flow is directed at the user. If you are working with hazardous materials or a large volume of toxic solvents, a laminar flow hood is not the right choice for you.
The purpose of a laminar flow hood is primarily to protect the sample, not the user. Therefore, they are ideal if you need to reduce sample contamination and you are working with non-hazardous materials.
When to Use a Fume Hood
A fume hood draws air from the inside the hood, to remove contaminants and solvent vapours generated in the workspace. There are two types: ducted and ductless. A ducted hood will extract contaminated air into an exhaust duct, and release it into the atmosphere. Ductless fume hoods filter the contaminated air using carbon and HEPA filters before releasing it back into the room. Ductless fume hoods are simpler to install but offer less protection against toxins. In both cases, the contaminated air removed from the hood workspace is replaced with air from the room.
Regardless of type, a fume hood's primary role is to protect the user. These hoods shield you from solvent vapours by actively removing them from your workspace. However, fume hoods provide little protection against sample contamination. In some cases they can make contamination of dust and other particles more likely, as they actively pull air from the room into the workspace. You should use a fume hood if you are working with hazardous materials. If you are unsure if your material should be handled in a fume hood, check the Safety Data Sheet for the material.
While a fume hood will provide some level of protection, the user is still exposed to the substance. For further protection when using very hazardous materials you should use a completely isolated environment, such as a glove box.
Laminar Flow Hood vs Fume Hood: Making the Choice
The table below compares the key properties of a laminar flow hood and fume hood.
Laminar Flow Hood | Fume Hood | |
---|---|---|
Purpose | Protect samples from contamination | Protect user from hazardous substances i.e., solvent vapours |
Air Circulation |
Filters incoming air before it enters the hood Air circulates through the chamber, then back into the room |
Air flows from the room through the main chamber Contaminated air is pulled out of the main chamber either through filters or an exhaust duct |
Weaknesses | Does not protect user from hazardous materials. LFH should not be used with hazardous materials or toxic solvents. | Does not protect samples from contamination. Will drag dust and impurities from the room into the fume hood. |
Applications |
Non-hazardous microbiology applications Preparing media plates & mammal/plant cultures Fabricating thin films (with non-hazardous solvents) and thin film devices Electronics inspections |
Some hazardous microbiology applications Working with hazardous materials Heavy solvent processing |
A laminar flow hood is ideal for protecting your samples when conducting sensitive experiments. Whereas a fume hood is suited to applications that involve the handling of hazardous or toxic substances. Understanding the purpose of the equipment and how they are different is critical to selecting the right hood for your needs.
How to Use a Laminar Flow Hood
Laminar Flow Hood Golden Rules
- Clean the hood with disinfectant before you use it.
- Organize your workspace to avoid cross contamination.
- Follow the correct working procedures to reduce the risk of contamination.
- Clean the hood again if you think the workspace might be contaminated.
Keeping the Hood Clean
Keeping the hood clean is one of the most important requirements to successful research in a laminar flow hood. Firstly, it is important to make sure your laminar flow hood is clean before any materials enter it. Once your experiment is up and running, it's just as important that the laminar flow hood remains clean throughout the experiment, especially for microbiological or molecular biological applications.



Even when the hood is not in use, we recommend you clean inside and outside regularly. Once a week, clean the surface area below and around the hood with a combination of 70% ethanol and a surface disinfectant. This helps maintain a contaminant-free environment ready for your next experiment.
Setting Up the Hood
Ossila laminar flow hoods have inbuilt particle counters, giving you live information about internal particle concentration. You can see when the environment is clean enough to use. It is common practice to run a laminar flow hood for at least 30 minutes before use. With our smart air sensing technology, we recommend running the hood for 20 minutes to allow the internal environment to stabilize.
The UV light is useful for removing contamination on the work surface. The light should be used before you start your experiment, you should never work in the hood while the UV light is on. While the UV light is effective, it should be part of a complete cleaning and preparation process. It's important to wipe down exposed surfaces before use as well.
Organizing Your Workspace
Arrange your materials and equipment to reduce redirection of air flow as much as possible. Do not overcrowd your working area as it can disrupt the air flow, rendering it less effective. Your set-up should facilitate minimal, slow movements while using the workspace.
Organize your equipment, waste containers, and reagent bottles to avoid placing used items near clean ones. It is crucial to avoid passing used items over clean items, especially in a vertical laminar flow hood. The waste receptacle should be placed on the side most convenient to you and away from other sterile materials. It should be tall enough to reduce the chances of cross contamination, and contaminated material should not be left in the laminar flow hood for long.
If using a vertical laminar flow hood, do not position yourself or your hands directly above sensitive samples. The downwards air flow can push contamination onto your samples.
If you are working in a horizontal laminar flow hood, position your samples (or any materials that you wish to remain uncontaminated) towards the back of the flow hood. Do not place your hands or other potentially contaminated materials (waste, used clean room tissues, pipettes, etc) behind these sample. If you do, any contamination will follow the air flow over your samples, risking contamination.
Working in a Laminar Flow Hood
While using a laminar flow hood provides protection, the cleanliness of the environment is only as good as your working procedures. Plus, the human body is a major source of contamination in the laboratory. In order to keep your working environment clean, it is important to follow the correct procedures. Through these easy tips and steps, you can prevent contamination and maintain a clean workspace. There are some recommended guidelines to follow:
When using a laminar flow hood, following proper working procedures is crucial. The above guidelines can help decrease the risk of contamination and ensure a clean working environment.
How Does a Laminar Flow Hood Work?
In settings and applications where a clean environment is essential, a laminar flow hood is a vital tool which ensures a contamination-free workspace by generating a continuous flow of clean air to remove airborne particles. Air is drawn through specialized filters which purify the air before it is directed into the hood. The motor and fan are specially designed to create laminar air flow in which the air moves smoothly through the hood.
Included with the Ossila Laminar Flow Hood
Ossila laminar flow hoods come fully equipped, unlike systems from other manufacturers. These components work together to keep the air clean and maintain a contaminant-free environment. The system includes:
- Fan and motor — Draws air into the unit and pushes it through the filter.
- Set of filters — This component traps airborne particles; usually a high-efficiency particulate air (HEPA) or an ultra-low penetration air (ULPA) filter.
- Particle sensor — Monitors the internal air quality and filter saturation.
- Differential pressure sensor — Monitors the laminar air flow and triggers an alert if the air flow changes.
- Control system — This includes switches for operating the fan and lights, speed controls, and additional features.
- UV light — Helps to keep the work surface free from biological contaminants.
- Stainless steel work surface — The area where tasks requiring a clean environment take place.
A Laminar Flow Hood in Action
Operating through a series of mechanical steps, a laminar flow hood removes particle contamination from the work environment. The fan pulls air from the room into the system. This air initially travels through a pre-filter to remove large particles. For finer filtration, air then passes through a HEPA or ULPA filter, which traps smaller particles and contamination. After filtration, the clean air is pushed into the work chamber in a laminar flow. It travels at a uniform speed from the filter to the front of the hood, removing and preventing any contamination.
In a vertical hood, the air is pushed from a filter located at the top of the hood and flows downward onto the work surface. In contrast, a horizontal hood directs the air flow from a rear-mounted filter straight to the user.
Control systems are another vital aspect of the hood's operation. Typically, this can include fan speed controls and environment monitoring sensors. These controls enable the user to customize the conditions inside the chamber according to their needs. Some models also come with additional features, such as built-in UV lights, when the hood is not in use.
The performance and efficacy of a laminar flow hood are determined by the laminarity of the air flow, which can be influenced by several air flow properties, and the design of the system.
Resources
You can test if the cleanliness of the air flow using settle plates and the surfaces using contact plates. To check that our laminar flow hood is suitable for microbiological uses, we tested for air and surface contamination.
Read more...
This short video guide shows you how to get started with your new equipment. It is easy to control the fan, lighting, and internal UV light.
Read more...
Regular and thorough cleaning of your laminar flow hood allows you to reliably conduct your experiments without risk of contamination.
Read more...
Microbiological laboratories have undergone modernization in the last decade. Through automation and advanced technology, the field has been transformed. Designing and setting up a microbiology laboratory requires careful planning, proper equipment, and adherence to safety standards. Well-structured microbiology laboratory can enhance research capabilities, improve efficiency and have an impact on scientific advancements.
Read more...